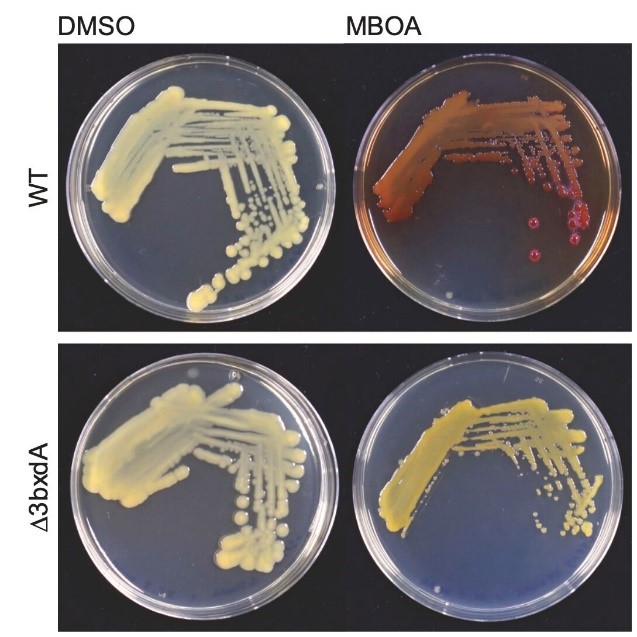
mutant

Discovering How Maize Root Bacteria Metabolize Host Exudates – A Story Of Red Art, Teamwork, and Serendipity
Published in Microbiology and Plant Science

The story began with an observation made away from home and together with colleagues. This discovery kept me busy for five years and was the biggest motivation during my PhD. Here is the development of the story in 7 acts...
Chapter 1: The observation on a Friday afternoon
During the first summer of my PhD, I visited the research group of Claude Becker at the Gregor Mendel Institute in Vienna. Niklas Schandry taught me the methodology to screen my collection of maize root bacteria for tolerance to benzoxazinoids, the main bioactive compounds of maize. In the first run – on a Friday afternoon – I observed a marked color change in the replicate wells of one of my bacterial cultures (Figure 1). These cultures changed the color from faint yellow to dark red in the presence of the benzoxazinoid MBOA. We suspected that this bacterial strain was metabolizing MBOA to AMPO, for which the genetic mechanism was unknown.

Chapter 2: Uncovering the dark red color
A month after returning from my research stay, I received an email from Eva Knoch, a member of the Becker team. She had performed metabolite analyses on my bacterial cultures to uncover the origin of the red color. She found that the dark red colored cultures were indeed forming AMPO! After confirming the chemical reaction, many questions turned in my head... How do these bacteria convert MBOA to AMPO, which enzyme and which gene is responsible for the reaction? Where does this trait occur? Do many bacteria carry this trait or just a few? Why do these bacteria metabolize MBOA to AMPO, to detoxify, as a defense against other bacteria, as a byproduct?
Chapter 3: Artwork in red by the maize root microbiome
Back in the lab I performed experiments to test whether the bacteria's color change to red in presence of MBOA would work also on solid agar plates. Indeed, this worked very well with pure cultures. From now on I had a useful tool to screen pure cultures for AMPO formation. This assay worked so well that I wanted to use it to find more AMPO-producing bacteria. My good PhD friend Valentin had some happy maize plants in the greenhouse and I could harvest the roots and plate them on MBOA plates. After six days of incubation – I paused my breath – when viewing the artwork in red as painted by the maize root microbiome on MBOA containing agar plates (Figure 2).

Chapter 4: Importance of phenotypic variation
Curiousity was awakened. I began to isolate, purify, and systematically characterize the bacteria that formed red colonies on MBOA plates. In total I found bacteria from five different genera belonging to two different phyla that metabolized MBOA to AMPO. I noticed two closely related isolates, both microbacteria, one of which formed AMPO and the other did not. Was this annoying variation? Following this key observation, I tested additional Microbacterium isolates – some forming AMPO, others not (Figure 3). Among the non-formers there were many bacterial isolates from Arabidopis, a plant that does not produce benzoxazinoids. This was consistent with the finding that root extracts from plants that do not produce benzoxazinoids, almost no red colonies were found. In other words, the Arabidopsis root microbiome is not ‘painting’ artwork in red on MBOA plates. This suggested that maize root bacteria have specialized to metabolise the specific metabolites of their host plant. This comparative work with bacteria of non-benzoxazinoid producing plants taught me an important lesson – phenoREDic variation was instrumental (to solve the genetic basis of AMPO formation, see below).

Chapter 5: When the collaborator calls you on Friday afternoon
To identify the genetic basis of AMPO formation, we sequenced the genomes of our collection of microbacteria and teamed up with Marco Kreuzer, a bioinformatician of the Bruggmann team at the University of Bern. Marco was comparing the genomes for associations with the strains’ varying phenotypes in AMPO formation. In a phone call on a Friday afternoon, he told me: “Hey Lisa, all AMPO-producing bacteria carry a gene cluster that is not present in the other non-AMPO-producing bacteria.” Marco sent me a first plot of the bxd gene cluster (Figure 4). This was another breath-taking moment on a Friday afternoon.

Figure 4: First-pass analysis of the bxd gene cluster
Chapter 6: Bacteria on a weekend trip
After identifying the responsible gene cluster, the next obvious goal was to find the gene, which was responsible for the MBOA-to-AMPO conversion. After quite some unsuccessful attempts trying heterologous expression in our lab, we realized that we need to team up with real pros in biochemistry. We contacted Matilde Florean and Tobias Koellner from the Max Planck Institute for Chemical Ecology in Jena, Germany. On my way home from a weekend trip to Hamburg (yes, my bacteria spent a weekend on the lake shore), I brought the bacteria to their lab. After a fun dinner at the Vietnamese restaurant, I knew that my bacteria were in good hands and I was optimistic that this plan would work! A few weeks later I got the good news from Matilde (yes, it was again on a Friday afternoon): The first gene in our cluster – bxdA – is coding for the enzyme that converts MBOA to AMPO in vitro! With this key new confirmation, we wrote the study up and submitted the manuscript for review. This was when my Ph.D. time was then over.
Chapter 7: Knockout mutants do not paint in red
The work then came to a sound end, again thanks to great team work. Let me explain: the reviewers of our manuscript were right in asking for in vivo confirmation for the activity of BxdA. Since there were no protocols for genetically modifying microbacteria, the alternative was to work with Sphingobium, which also form AMPO. Anlun aka Alan Wei and Christine Pestalozzi created bxdA knockout mutants in Sphingobium. The key finding was that the bxdA knockout mutants were unable to color the MBOA agar plates in red. And again, Alan showed me these agar plates on a Friday afternoon!
Figure 5: Sphingobium bxdA knockout mutants do not show a red color on MBOA-containing agar plates
Epilogue: Team work was the key
Apart from the scientific conclusions, there are numerous take homes from this science journey: Allow serendipity, it all started with an unexpected initial observation, which could hardly be simpler: a culture turns red. Looking back to five intense years of work, it is rewarding to see where curiosity, dedication and passion lead you to! In retrospect, the key to the success of this interdisciplinary work was to team up with the right collaborators. As a fun fact, the collaborations in this work all followed the same fil rouge in communicating their critical results – they always informed me on Friday afternoons about the exciting news of their experiments. Taking the reverse conclusion: make sure to collaborate with people that work on Friday afternoons.
Follow the Topic
-
Nature Communications
An open access, multidisciplinary journal dedicated to publishing high-quality research in all areas of the biological, health, physical, chemical and Earth sciences.
Related Collections
With Collections, you can get published faster and increase your visibility.
Women's Health
Publishing Model: Hybrid
Deadline: Ongoing
Biosensing
Publishing Model: Hybrid
Deadline: Sep 30, 2026





Please sign in or register for FREE
If you are a registered user on Research Communities by Springer Nature, please sign in